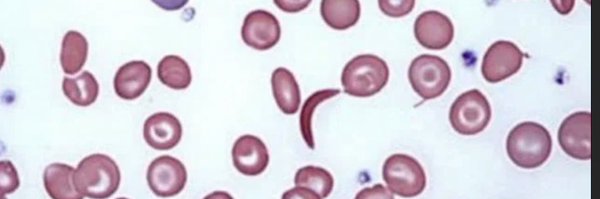
pedshemepulmdoc Profile Banner

Shaina Willen MD
@pedshemepulmdoc
Followers
81
Following
95
Media
1
Statuses
11
Wife, mom, pediatrician, hematologist/oncologist, pulmonologist, and researcher working to improve the lives of people living with #sicklecell- posts are my own
Joined May 2022
The #ATS2023 Women’s Forum has begun!! So excited for Dr. Lorraine Ware, winner of the Elizabeth Rich Award. Can’t think of a more deserving person!! Grateful for her mentorship and friendship for almost 20 years!!!
0
6
40
You’d think that having had COVID-19 once, your children have antibodies to protect them from repeat infections. But new research finds that #Omicron doesn’t go by that logic and that unvaccinated children are still susceptible. https://t.co/UrLtmDndU6
0
4
5
Dr. Shaina Willen a 2022 @UCDavisMed Dean’s Fellow in Environmental Health Sciences. Congratulations Dr. Willen! @UCDavisChildren @UCDavisHealth @pedshemepulmdoc
1
3
6
Today we are continuing our series of features from our Pioneers of Hope article in Hope Magazine. We are pleased to share a bit about Michael DeBaun, MD, MPH, Pediatric Hematology & Oncology. To read the full piece visit: https://t.co/LRBG29pn5y
0
0
0
Well, this came out just in time for a talk I'm giving tomorrow. Annual decline in FEV1 comparable between sickle cell disease and cystic fibrosis.
ashpublications.org
TO THE EDITOR:
4
3
15